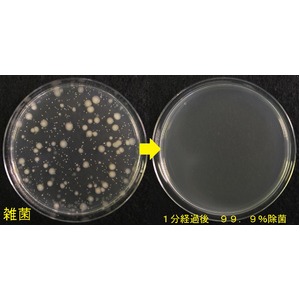

徹底した検品、商品を熟知したカスタマーサポートをご用意
高品質の商品を低価格でご提供

楽天と激安比較してみてください
もしもの時に!!アドレンズp.o.v. 『 JOHN LENNON モデル 』 JL-CL(オプティカル クリスタル)とはDescription
アドレンズ
¥10736円

もしもの時に!!アドレンズp.o.v. 『 JOHN LENNON モデル 』 JL-CL(オプティカル クリスタル)は激安価格につき申し訳ございませんが
在庫わずかとなっております(_ _。)
☆ちょいセクシーな大きめサイズの専門店☆





商品説明a review

通常使用も、もちろんのこと、
災害時、緊急時にも、大活躍!!
★2012年、ビートルズデビュー50周年を記念して、『アドレンズp.o.v.』に新製品が発売!
★ジョンレノンのメガネをイメージした、『オプティカル』『サン』『イマジン』の3種×3色のラインナップ!
■世界初の液体レンズテクノロジーで度数が調整可能なメガネ。
■適用度数は-4.5D(近視)から+3.5D(遠視・老眼)までで、左右それぞれの度数を調節します。
■度数の調整後はダイヤルをフレームから取り外し、レンズを密封して使用できます。
■衝撃に強く、耐久性に優れたポリカーボネート(レンズ部分)、TR90(フレーム部分)を採用しています。
■レンズ内の液体は、人体に無害なシリコンオイルを使用しています。
■眼鏡枠寸法:34□29 135mm
■フレーム(テンプル幅、形状)・鼻パッドを調整してフィッティング可能。
■瞳孔間距離:66mm
スペック/成分/効果/メーカー/型番/口コミreview
【商品名】
もしもの時に!!アドレンズp.o.v. 『 JOHN LENNON モデル 』 JL-CL(オプティカル クリスタル)
【材質】
レンズの素材:プラスチック(ポリカーボネート)
レンズ枠 プラスチック(TR90)
テンプル プラスチック(TR90)
【付属品】
本体:ケース:取り扱い説明書
【生産国】
マレーシア
【特記事項】
乱視矯正には、適しません。
【一般医療器番号】
35065000
生活用品・インテリア・雑貨 その他の生活雑貨
口コミ・感想 更新中・・・
アドレンズ
JL-CL(オプティカル クリスタル)
おすすめ商品覧spec